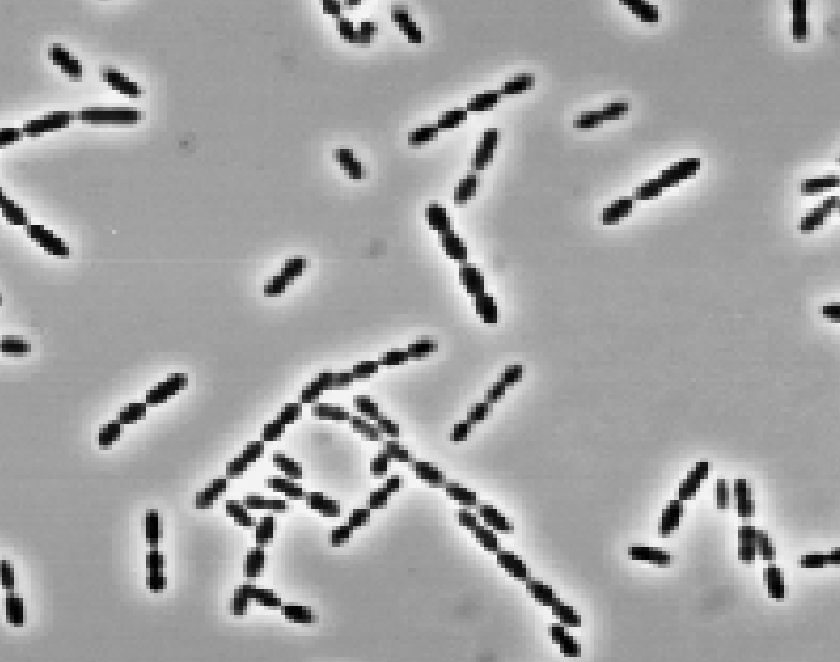
Screenshot 2025-07-30 at 11.31.19 AM

Blautia
Blautia is a genus of bacteria known for contributing to the maintenance of intestinal immune homeostasis, and it may also play a role in stimulating serotonin release.
Taxonomic Level: Genus
Family: Lachnospiraceae
Properties: Gram-positive, Anaerobic, Nonsporulating
Additional Information: Blautia is a genus of microbes known to contribute to the maintenance of intestinal immune homeostasis. According to a study on the microbiota of obese children, a decreased abundance of B. luti and B. wexlerae species in the gut is often associated with obesity and metabolic issues such as resistance to insulin and related inflammatory markers. Furthermore, a decreased abundance of Blautia was significantly associated with visceral (abdominal) fat accumulation in adults. It has also been proposed that Blautia contains a specific enzyme which can convert tryptophan into tryptamine. Tryptamine then stimulates specialized cells in the GI tract to release serotonin.
.png?width=3000&height=1170&name=NirvanaBiome_logo_fullcolor_RGB-1500%20(1).png)
.png?width=1500&height=585&name=NirvanaBiome_logo_fullcolor_RGB-1500%20(1).png)



